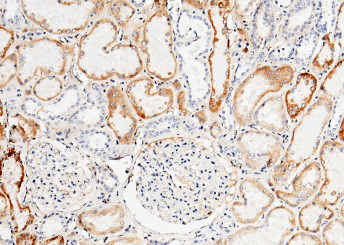
Anti-TFPI Monoclonal Recombinant Antibody

Cookie preferences
This website uses cookies, which are necessary for the technical operation of the website and are always set. Other cookies, which increase the comfort when using this website, are used for direct advertising or to facilitate interaction with other websites and social networks, are only set with your consent.
Configuration
Technically required
These cookies are necessary for the basic functions of the shop.
"Allow all cookies" cookie
"Decline all cookies" cookie
CSRF token
Cookie preferences
Currency change
Customer-specific caching
FACT-Finder tracking
Individual prices
Selected shop
Session
Comfort functions
These cookies are used to make the shopping experience even more appealing, for example for the recognition of the visitor.
Note
Show the facebook fanpage in the right blod sidebar
Statistics & Tracking
Affiliate program
Conversion and usertracking via Google Tag Manager
Track device being used
| Item number | Size | Datasheet | Manual | SDS | Delivery time | Quantity | Price |
|---|---|---|---|---|---|---|---|
| E-AN300197P.20 | 20 µl | - |
7 - 16 business days* |
182.00€
|
|||
| E-AN300197P.100 | 100 µl | - |
7 - 16 business days* |
462.00€
|
If you have any questions, please use our Contact Form.
You can also order by e-mail: info@biomol.com
Larger quantity required? Request bulk
You can also order by e-mail: info@biomol.com
Larger quantity required? Request bulk
Tissue factor pathway inhibitor (TFPI) is the natural inhibitor of TF coagulant and signaling... more
Product information "Anti-TFPI Monoclonal Recombinant Antibody"
Tissue factor pathway inhibitor (TFPI) is the natural inhibitor of TF coagulant and signaling activities. It is a Kunitz-type serine proteinase inhibitor that down-regulates tissue factor-initiated blood coagulation. With its Kunitz domains, TFPI exhibits significant homology with human inter-alpha-trypson inhibitor and bovin basic pancreatic trypsin inhibitor. TFPI is the natural inhibitor of TF coagulant and signaling activities. The importance of TFPI in the regulation of blood coagulation is emphasized by how its activity is modulated in human disease. In a factor (F) Xa-dependent feedback system, TFPI binds directly and inhibits the TF-FVII/FVIIa complex. Normally, TFPI exists in plasma both as a full-length molecule and as variably carboxy-terminal truncated forms. TFPI also circulates in complex with plasma lipoproteins. The levels and the dual inhibitor effect of TFPI on FXa and TF-FVII/FVIIa complex offers insight into the mechanisms of various pathological conditions triggered by TF. TFPI may play an important role in modulating TF-induced thrombogenesis and it may also provide a unique therapeutic approach for prophylaxis and/or treatment of various diseases. In addition, studies have shown that TFPI exhibits antiangiogenic and antimetastatic effects in vitro and in vivo. In animal models of experimental metastasis, both circulating and tumor cell-associated TFPI are shown to significantly reduce tumor cell-induced coagulation activation and lung metastasis. Protein function: Inhibits factor X (X(a)) directly and, in a Xa-dependent way, inhibits VIIa/tissue factor activity, presumably by forming a quaternary Xa/LACI/VIIa/TF complex. It possesses an antithrombotic action and also the ability to associate with lipoproteins in plasma. [The UniProt Consortium]
| Keywords: | EPI, LACI, TFPI, Extrinsic pathway inhibitor, Tissue factor pathway inhibitor, Lipoprotein-associated coagulation inhibitor, Recombinant TFPI Monoclonal Antibody |
| Supplier: | Elabscience |
| Supplier-Nr: | E-AN300197P |
Properties
| Application: | IHC (paraffin) |
| Antibody Type: | Monoclonal |
| Clone: | 7C10 |
| Conjugate: | No |
| Host: | Rabbit |
| Species reactivity: | human |
| Immunogen: | Recombinant Human TFPI protein |
| Format: | Purified |
Database Information
| KEGG ID : | K03909 | Matching products |
| UniProt ID : | P10646 | Matching products |
| Gene ID : | GeneID 7035 | Matching products |
Handling & Safety
| Storage: | +4°C (avoid repeat freezing and thawing cycles) |
| Shipping: | +4°C (International: +4°C) |
| Signal Word: | Warning |
| GHS Hazard Pictograms: |
|
| H Phrases: | H317 |
| P Phrases: | P261, P272, P280, P302+352, P333+313 |
Caution
Our products are for laboratory research use only: Not for administration to humans!
Our products are for laboratory research use only: Not for administration to humans!
Information about the product reference will follow.
more
You will get a certificate here
Viewed

